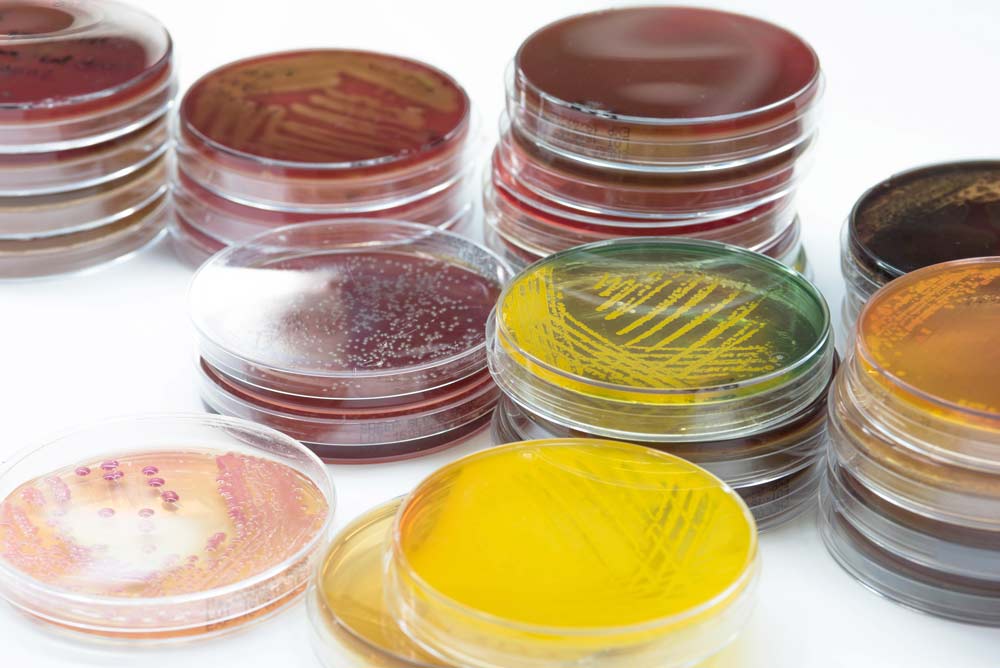
Аргозные гели

Агароза — получение и свойства
- Главная страница
- Пресс-центр
- Статьи
- Агароза — получение и свойства
Агароза — это линейный полисахарид, являющийся компонентом агара, аналогично с амилозой, входящей в состав крахмала. Агарозный гель, применяемый для электрофореза и иммунодиффузии, не содержит остаточных сульфогрупп, изначально содержащихся в агаре. Их устраняют, чтобы исключить электроосмос при проведении фореза. В легкоплавкую агарозу, наоборот, добавляют определённые группы, чтобы скорректировать физические свойства вещества.
Агарозу получают из красных морских водорослей (Gracilaria, Gelidium, Ahnfeltia). Она представляет собой линейный полимер с молекулярной массой 104-105, цепь которого состоит из beta-D-галактопиранозы и 3,6-ангидро-alfa-L-галактопиранозы.
Гелеобразование происходит за счёт построения пространственной структуры из пучка полимерных нитей, на основе их водородной связи. Для некоторых видов полисахарида достаточно концентрации 0,3% для образования прочного, крупнопористого геля. При температуре от 70 до 96°C (зависит от вида агарозы) растворы «плавятся», то есть, преобразуются в прозрачную жидкость. При этом 1% раствор вещества обладает вязкостью в 10-25 сП. Этот показатель приблизительно равен 50% раствору сахарозы в условиях комнатной температуры.

Отличительная особенность растворов агарозы — ярко выраженное явление гистерезиса. Они способны затвердевать в гелевую форму при температурах от 36 до 42°C (30°C для легкоплавких типов). Это значительно упрощает работу с жидкой агарозой — можно не беспокоиться, что произойдёт её досрочное затвердевание. Кроме того, расплавленный с помощью кипящей водяной бани полисахарид можно сначала остудить до 50-55°C, и только после этого распределять по формам. Такой метод гораздо удобнее и не вызывает сильных температурных деформаций.
Агарозные гели не обладают высокой прозрачностью, но дело здесь не в содержании примесей, а, скорее, в «кристаллизации» самого материала, что говорит о чистоте полисахарида.
Застывший гель агарозы может становиться плотнее, выделяя часть влаги. Сначала уплотнение происходит быстро, затем значительно замедляется. Несмотря на это, состав рекомендуется выдерживать до начала опытов около 12 часов. Если это стеклянные пластины для горизонтального электрофореза, их помещают во влажную камеру. У более насыщенных агарозных гелей сильнее выражается уплотнение.
Температура плавления и гелеобразования напрямую связана с процентным содержанием метоксильных групп в составе агарозы (от 3 до 4%), поскольку они усложняют эти процессы. Кроме того, полисахарид содержит эфиры серной кислоты, которые оказывают влияние на температуры и на сам процесс фореза.
Различные буферы, детергенты и другие вещества, которые добавляют в горячий раствор (50-60°C), не оказывают влияния на процесс застывания агарозы. Чего нельзя сказать о добавках, которые диссоциируют водородные связи. Например, обычные агарозные материалы с 6М мочевиной плавятся за 1,5 минуты при температуре в 75°C, но не способны застыть за час при 20°C. Не влияет на гелеобразование и кислород, поэтому плоские гели для горизонтального электрофореза готовятся с помощью заливки дозы полисахарида на пластину из стекла. Тем не менее, при добавлении буферов рекомендуется деаэрировать горячую смесь под вакуумом.
Нужная концентрация агарозы (пористость геля) определяется по размеру разделяемых макромолекул. Например, приблизительная величина пор 2% материала примерно равна диаметру сферической молекулы биополимера, обладающего атомной массой в 50 миллионов Дальтон. Чем выше концентрация, тем меньше должны быть фракционируемые фрагменты. Более концентрированные агарозные гели применяются для гель-хроматографии. При проведении электрофореза важна высокая проницаемость пор для биополимеров. Это помогает замедлить их миграцию в электрополе.
и приглашать на предстоящие выставки и семинары

